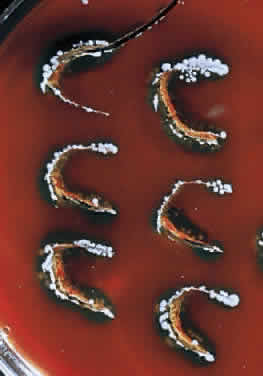
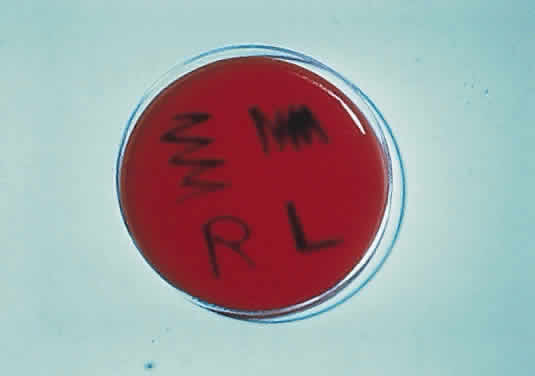

STAPHYLOCOCCI
Staphylococci are among the most common bacteria encountered in ocular infections. Staphylococcus aureus (coagulase-positive staphylococcus) is generally considered to be a pathogenic organism. The coagulase-negative staphylococci include Staphylococcus epidermidis, which is thought to be part of the normal body flora. There are at least 14 other species of coagulase-negative staphylococci that are rarely associated with infectious keratitis.31
During microscopic examination, staphylococci almost always appear Gram-positive, are spherical with a mean diameter of approximately 1 mm, and are seen extracellularly. Old cultures or scrapings from antibiotic-treated cases may show Gramnegative staining characteristics. Although grape-like clusters are frequently seen in scrapings or smears from nonocular tissues, these are unusual in scrapings from corneal ulcers, in which single cocci or clusters of two to six cocci are observed. Two species, S. epidermidis and S. aureus, cannot be distinguished by Gram stain; however they show distinct characteristics in culture. In general the staphylococci are easily cultured on standard bacteriologic media (see laboratory section) and grow rapidly in incubation at 37°C. They do not have a distinctive odor and grow in the presence or absence of oxygen. Typical colonies are round, flat, smooth, and several millimeters in diameter by 48 hours (Fig. 1). S. aureus colonies show beta hemolysis (clear zones of hemolysis on blood agar) and some degree of pigmentation (light cream to golden yellow). In contrast, S. epidermidis colonies are usually nonhemolytic and rarely exhibit pigmentation.
|
Because S. epidermidis is often a nonpathogenic component of normal conjunctival and eyelid flora, it is important to differentiate it from the often pathogenic S. aureus. The usual approach is to perform a catalase test, which is positive for staphylococcus but negative for streptococcus. This is followed by a coagulase test, which is positive for S. aureus and negative for S. epidermidis. Typing of S. aureus strains has indicated that the vast majority of S. aureus infections are caused by organisms normally carried by the patient.32,33 With the emergence of methicillin-resistant S. aureus (MRSA), antibiotic susceptibility testing of corneal S. aureus isolates has become essential. MRSA should be suspected in hospitalized patients. If MRSA infection is discovered, consultation with an infectious disease specialist or hospital epidemiologist may be warranted in order to determine whether the patient is a carrier of MRSA so that appropriate treatment may be initiated.
S. aureus and the coagulase-negative staphylococci produce corneal ulcerations that may appear similar; however, those caused by S. aureus are in general more severe and are associated with more complications. The production of extracellular proteins and enzymes by S. aureus helps facilitate the spread of infection by combating host defense mechanisms and destroying healthy corneal tissue.1 A staphylococcal ulcer may present as either a central, infected ulcer or a marginal, toxic (allergic) ulcer. Most commonly, S. aureus is the responsible organism; however, coagulase-negative staphylococci may be causative agents in eyes with prior corneal disease such as bullous keratopathy or herpes simplex, or with prolonged wearing of a bandage contact lens.27
Clinically, the infected staphylococcal corneal ulcer presents with a yellow-white, well-demarcated area of infiltrate, which appears directly beneath an epithelial defect (Fig. 2). On occasion, multiple, small satellite lesions may develop. The infection may initially be superficial; however, if inadequately treated it can produce a mid to deep stromal abscess that may eventually lead to perforation. Stromal edema and white blood cell migration frequently surround the dense infiltrate and clear as the infection comes under control. Although there may be a marked anterior chamber reaction with hypopyon, the ulcer more frequently is indolent, with only a minimal inflammatory reaction.34
The more peripheral marginal infiltrate is sterile and is caused by a hypersensitivity reaction to the exotoxin or the bacterial antigens of S. aureus.35,36 The peripheral infiltrates usually are associated with blepharitis or conjunctivitis and frequently begin in the areas where the lid margins cross the limbus (at 2-, 4-, 8-, and 10-o'clock positions). The lesions often have a typical clinical appearance characterized by one or more small, well-circumscribed anterior stromal infiltrates, with a lucid interval between them and the limbus (Fig. 3). Although the epithelium is usually intact, it may break down, leading to ulceration, scarring, and neovascularization.
STREPTOCOCCI
The streptococci consist of a diverse collection of organisms that have been classified into many different groups based on antigenic properties, types of hemolysis, and growth characteristics.31 The most common of these organisms, cultured from infected corneal ulcers, are Streptococcus pneumoniae (pneumococcus), S. viridans (alpha-hemolytic streptococcus), S. pyogenes (beta-hemolytic streptococcus), and the group D streptococci S. faecalis (nonhemolytic streptococcus).
Although S. pneumoniae was once the most common cause of bacterial keratitis, it has been surpassed by Staphylococcus and Pseudomonas7,8 in the United States. However, S. pneumoniae remains the most common cause of bacterial keratitis in the developing world.30 S. viridans ulcers occur more frequently than those caused by the more virulent S. pyogenes, presumably because the former may be part of the normal flora of the upper respiratory tract. The less common E. faecalis (enterococcus) corneal infections have been reported in either immunosuppressed hosts or after epithelial corneal injury and direct transmission from the gastrointestinal tract.25 E. faecalis is the third leading cause of nosocomial infection in the U.S., and recently cases of vancomycin-resistant enterococcus have been reported.37,38
The microscopic appearance of all streptococci, except for pneumococcus, is similar. Smears taken from culture material show Gram-positive cocci in chains of varying lengths. Scrapings taken directly from infected ocular tissues may not demonstrate the chain effect, and differentiation from staphylococci may be difficult (Fig. 4). The morphologic characteristics of the Staphylococcus and Streptococcus organisms are outlined in Table 3.
|
TABLE 18-3. Morphologic Characteristics of Staphylococcus and Nonpneumococcal
Streptococcus on Gram-Stained Smear
| Factor | Staphylococcus | Streptococcus |
| Size | Larger | Smaller |
| Shape | Spherical | More oval |
| Associated with polymorphonuclear leukocytes | Yes | No (except for S. pyogenes) |
The Gram stain of S. pneumoniae differs from that of other Streptococcus organisms by the presence of a polysaccharide capsule surrounding the lancet-shaped diplococci. Streptococci grow best on blood agar or nutritionally enriched media such as brain-heart infusion medium. Identification of the different species is aided by the hemolytic nature of the organism. With alpha hemolysis, the red blood cells are not completely lysed and a green color change is observed in the surrounding blood agar. With beta hemolysis, there is complete lysis of the red blood cells in the agar surrounding the Streptococcus colony. In general, the colonies of Streptococcus are elevated but quite small and measure between 1 and 2 mm in diameter. The pneumococci produce alpha hemolysis and may be differentiated in culture from S. viridans by the non-elevated, pitted appearance of the pneumococcal colony at 48 hours. In addition, the pneumococci produce capsules that impart a more translucent appearance to the colony.
Because the 24-hour culture of pneumococci may be easily confused with that of S. viridans (α-hemolytic streptococcus), laboratory tests are needed to make a definitive identification. Optochin susceptibility and bile solubility suggest S. pneumoniae.
Because all streptococci are fermentative organisms and lack the enzyme catalase, this characteristic may be used to help differentiate the nonhemolytic streptococci from similar-appearing colonies of Staphylococcus. The catalase test is useful in quickly determining whether a colony is a Streptococcus.
Although S. pneumoniae is an inhabitant of the upper respiratory tract in approximately 50% of normal human adults, it also is frequently found in the conjunctiva and lacrimal drainage apparatus. This close anatomical proximity to the cornea provides a source of organisms for possible infection. Any minor corneal trauma associated with disruption in the epithelium may lead to rapid invasion by this organism. The virulence of the S. pneumoniae organism is influenced by its polysaccharide capsule, which is serologically specific for more than 80 serotypes.4 Ocular isolates of these infections, however, do not seem to be caused by any particular pneumococcal serotype.39
Corneal ulcers caused by S. pneumoniae are typically described as serpiginous or creeping and most often spread toward the center of the cornea. They are characterized by a gray-yellow disc-shaped ulcer with an overhanging margin at the advancing edge (Fig. 5). The ulcer usually progresses rapidly, extending into the deep stroma and often leading to corneal perforation. Extensive damage to corneal tissue, as well as a characteristic sterile hypopyon, are caused by the rapid production of bacterial exotoxin within the stroma.40,41
|
Streptococcus viridans (alpha streptococcus), although of low-grade pathogenicity, may be a cause of corneal ulceration, particularly in the locally immunosuppressed host.42 The organism produces a characteristically indolent, anterior stromal inflammatory reaction that is slow to progress and that may be accompanied by a minimal to moderate anterior chamber reaction. The ulcer is usually well circumscribed, gray-white, “dry” in appearance, and lying beneath a well-demarcated epithelial defect (Fig. 6). Because the organism is of relatively low-grade pathogenicity, the infection responds rapidly to specific antibiotic therapy.
|
Infectious crystalline keratopathy is most commonly associated with S. viridans infection.43–45 This keratitis is characterized by discrete, white, crystalline, or fern-like stromal opacities, often under an intact epithelium, that are slowly progressive and have little associated corneal inflammation (Fig. 7). There is a strong association with prior topical corticosteroid therapy or penetrating keratoplasty. The condition has been termed infectious crystalline keratopathy and also has been reported with other organisms, including Haemophilus aphrophilus, Peptostreptococcus, and Staphylococcus epidermidis, as well as the fungal infections Alternaria and Candida tropicalis.46–49
|
A corneal biopsy may be necessary to gain access to the “crystalline” infiltrates for identification and culture of organisms. This may be accomplished using a disposable 2-mm dermatologic biopsy punch. These infections may be extremely resistant to therapy, requiring an extended course of antibiotics.
Streptococcus pyogenes (group A Streptococcus), although an important pathogen in other areas of medicine, is an infrequent cause of corneal infection. Marginal corneal ulcers associated with dacryocystitis have been reported with this organism.56 These marginal ulcers appear similar to the catarrhal ulcers associated with staphylococcal blepharitis. They may result from either a hypersensitivity or toxic response to the organism or from direct infection of the cornea.50
Enterococcus, a common organism found in the gastrointestinal tract, may produce a corneal ulcer in the presence of severely impaired host resistance or after epithelial injury. The organism produces a rapid and severe inflammatory response that can be devastating to the eye.

6 mm
6 mm

